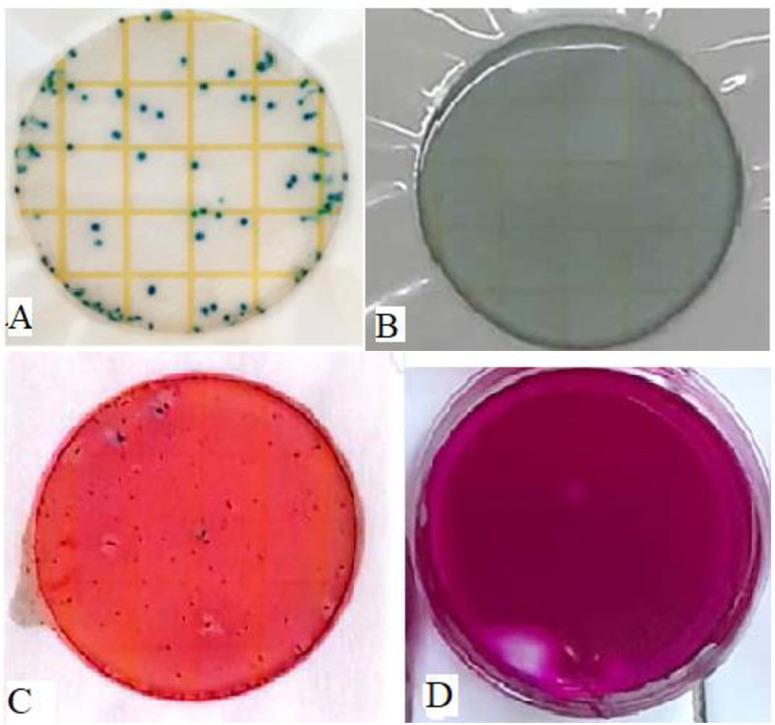
https://cdn.ncbi.nlm.nih.gov/pmc/blobs/b52c/12410813/4fe865ada9f4/pone.0330987.g004.jpg
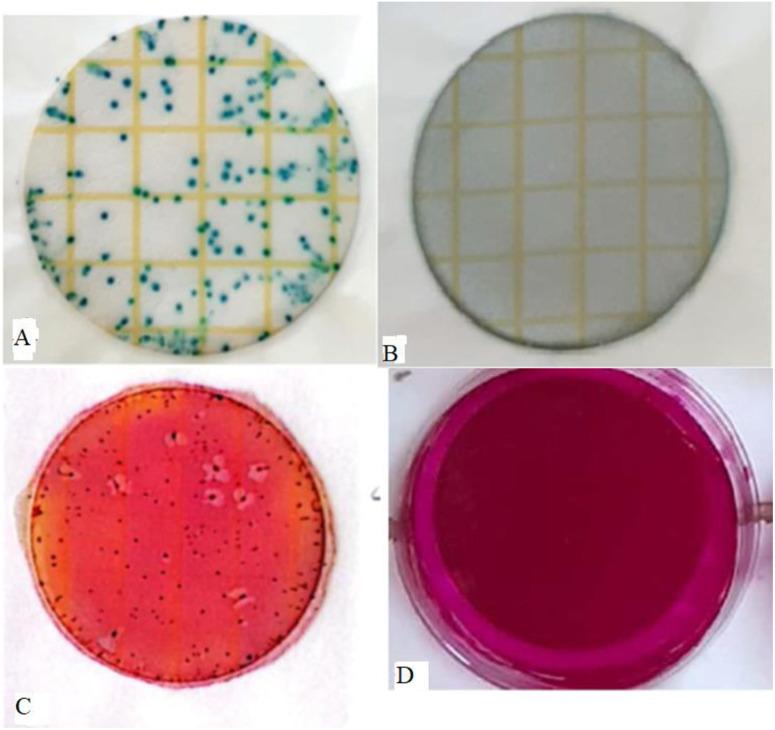
https://cdn.ncbi.nlm.nih.gov/pmc/blobs/b52c/12410813/3449c4fcb2f6/pone.0330987.g002.jpg

对浅井水的病原体杀灭剂——假败酱(沉睡晨植)进行的调查揭示了一种水消毒的潜在替代方法。
Investigation of Waltheria indica L. (sleepy morning plant) as pathogen killing agent from shallow well water revealed a potential alternative for water disinfection.
作者信息
Ilunde Josephat, Mpumi Nelson, Mwema Mwema Felix, Machunda Revocatus L
机构信息
School of Materials, Energy, Water and Environmental Sciences (MEWES), The Nelson Mandela African Institution of Science and Technology (NM-AIST), Arusha, Tanzania.
出版信息
PLoS One. 2025 Sep 4;20(9):e0330987. doi: 10.1371/journal.pone.0330987. eCollection 2025.
In many parts of the world, shallow well drinking water is contaminated and often consumed without treatment, contributing to over 3.4 million deaths annually due to water-related diseases. This research aims to assess the efficacy of Waltheria indica plant root extracts as an affordable method for disinfecting shallow well water in rural Tanzania. Laboratory experiments were conducted using dried plant roots in powdered form, as well as soaked and boiled extracts, to test their effectiveness in eliminating Escherichia coli and total coliforms at varying concentrations and contact times. Contaminated water samples were collected from shallow wells in the Misungwi district, Tanzania, and treated using all three forms of Waltheria indica extracts. Phytochemical profiling of the plant root extracts was performed using Liquid Chromatography tandem Mass Spectrometry (LC-MS/MS) to identify potential antimicrobial compounds. The disinfection efficacy was evaluated using a flocculator with 1-litre beakers to determine bacterial removal and the effects on key physicochemical parameters. Results showed that all three extract forms significantly reduced E. coli and total coliforms, achieving up to 100% reduction within 12 hours. The soaked extract was most effective, reducing E. coli and total coliforms by approximately 94.3% and 93.8%, respectively, followed by the boiled extract (83.9% and 85.8%) and the powdered form (81.9% and 68.2%). The treated water's pH and total dissolved solids (TDS) were not significantly affected across all treatments. However, turbidity levels remained above the acceptable limit of 5 NTU, indicating the need for further optimization. Overall, the results suggest that Waltheria indica plant root extracts have strong potential as a natural, low-cost water disinfectant.
在世界许多地方,浅井水受到污染,且常常未经处理就被饮用,每年导致超过340万人死于与水相关的疾病。本研究旨在评估椭圆叶刺蒴麻植物根提取物作为一种经济实惠的方法对坦桑尼亚农村浅井水进行消毒的效果。使用粉末状的干燥植物根以及浸泡和煮沸后的提取物进行了实验室实验,以测试它们在不同浓度和接触时间下消除大肠杆菌和总大肠菌群的有效性。从坦桑尼亚米松圭区的浅井中采集受污染的水样,并使用椭圆叶刺蒴麻提取物的所有三种形式进行处理。使用液相色谱串联质谱法(LC-MS/MS)对植物根提取物进行植物化学分析,以鉴定潜在的抗菌化合物。使用带有1升烧杯的絮凝器评估消毒效果,以确定细菌去除情况以及对关键理化参数的影响。结果表明,所有三种提取物形式均显著降低了大肠杆菌和总大肠菌群,在12小时内实现了高达100%的减少。浸泡后的提取物最有效,分别将大肠杆菌和总大肠菌群减少了约94.3%和93.8%,其次是煮沸后的提取物(83.9%和85.8%)和粉末形式(81.9%和68.2%)。所有处理对处理后水的pH值和总溶解固体(TDS)均无显著影响。然而,浊度水平仍高于5 NTU的可接受限值,表明需要进一步优化。总体而言,结果表明椭圆叶刺蒴麻植物根提取物作为一种天然、低成本的水消毒剂具有很大潜力。